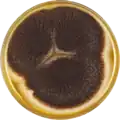
Aspergillus saccharolyticus growing on MEAOX plate

| Aspergillus saccharolyticus | |
|---|---|
| Scientific classification | |
| Domain: | Eukaryota |
| Kingdom: | Fungi |
| Division: | Ascomycota |
| Class: | Eurotiomycetes |
| Order: | Eurotiales |
| Family: | Aspergillaceae |
| Genus: | Aspergillus |
| Species: | A. saccharolyticus |
| Binomial name | |
| Aspergillus saccharolyticus A. Sørensen, P. Lübeck & Frisvad 2011[1] | |
| Type strain | |
| AS-2011, CBS 127449, IBT 28509[2] | |
Aspergillus saccharolyticus is a species of fungus in the genus Aspergillus. It belongs to the group of black Aspergilli which are important industrial workhorses.[3][4][5] A. saccharolyticus belongs to the Nigri section. The species was first described in 2008.[1] It was isolated from under a wooden toilet seat in Denmark.[1] The genome of A. sclerotiicarbonarius was sequenced and published in 2014 as part of the Aspergillus whole-genome sequencing project – a project dedicated to performing whole-genome sequencing of all members of the genus Aspergillus.[6] The genome assembly size was 37.62 Mbp.[6]
Growth and morphology
A. saccharolyticus has been cultivated on both Czapek yeast extract agar (CYA) plates and Malt Extract Agar Oxoid® (MEAOX) plates. The growth morphology of the colonies can be seen in the pictures below.
 Aspergillus saccharolyticus growing on CYA plate
Aspergillus saccharolyticus growing on CYA plate Aspergillus saccharolyticus growing on MEAOX plate
Aspergillus saccharolyticus growing on MEAOX plate
References
- 1 2 3 Noonim, P.; Mahakarnchanakul, W.; Varga, J.; Frisvad, J. C.; Samson, R. A. Two novel species of Aspergillus section Nigri from Thai coffee beans. Int. J. Syst. Evol. Microbiol. 2008, 58, 1727–1734, doi:10.1099/ijs.0.65694-0.
- ↑ "Aspergillus saccharolyticus". www.uniprot.org.
- ↑ Pel, H. J.; de Winde, J. H.; Archer, D. B.; Dyer, P. S.; Hofmann, G.; Schaap, P. J.; Turner, G.; de Vries, R. P.; Albang, R.; Albermann, K.; Andersen, M. R.; Bendtsen, J. D.; Benen, J. A. E.; van den Berg, M.; Breestraat, S.; Caddick, M. X.; Contreras, R.; Cornell, M.; Coutinho, P. M.; Danchin, E. G. J.; Debets, A. J. M.; Dekker, P.; van Dijck, P. W. M.; van Dijk, A.; Dijkhuizen, L.; Driessen, A. J. M.; d’Enfert, C.; Geysens, S.; Goosen, C.; Groot, G. S. P.; de Groot, P. W. J.; Guillemette, T.; Henrissat, B.; Herweijer, M.; van den Hombergh, J. P. T. W.; van den Hondel, C. A. M. J. J.; van der Heijden, R. T. J. M.; van der Kaaij, R. M.; Klis, F. M.; Kools, H. J.; Kubicek, C. P.; van Kuyk, P. A.; Lauber, J.; Lu, X.; van der Maarel, M. J. E. C.; Meulenberg, R.; Menke, H.; Mortimer, M. A.; Nielsen, J.; Oliver, S. G.; Olsthoorn, M.; Pal, K.; van Peij, N. N. M. E.; Ram, A. F. J.; Rinas, U.; Roubos, J. A.; Sagt, C. M. J.; Schmoll, M.; Sun, J.; Ussery, D.; Varga, J.; Vervecken, W.; van de Vondervoort, P. J. J.; Wedler, H.; Wösten, H. A. B.; Zeng, A.-P.; van Ooyen, A. J. J.; Visser, J.; Stam, H. Genome sequencing and analysis of the versatile cell factory Aspergillus niger CBS 513.88. Nat. Biotechnol. 2007, 25, 221–231, doi:10.1038/nbt1282.
- ↑ Goldberg, I.; Rokem, J. S.; Pines, O. Organic acids: old metabolites, new themes. Journal of Chemical Technology & Biotechnology 2006, 81, 1601–1611, doi:10.1002/jctb.1590.
- ↑ Pariza, M. W.; Foster, E. M. Determining the Safety of Enzymes Used in Food Processing. Journal of Food Protection 1983, 46, 453–468, doi:10.4315/0362-028X-46.5.453.
- 1 2 "Home - Aspergillus saccharolyticus JOP 1030-1 v1.0". Archived from the original on 2018-09-07. Retrieved 2018-09-07.
Further reading
- Sørensen, Annette; Andersen, Julie Juel; Ahring, Birgitte K.; Teller, Philip J.; Lübeck, Mette (September 2014). "Screening of carbon sources for beta-glucosidase production by Aspergillus saccharolyticus". International Biodeterioration & Biodegradation. 93: 78–83. doi:10.1016/j.ibiod.2014.05.011.
- Yang, Lei; Lübeck, Mette; Ahring, Birgitte K.; Lübeck, Peter S. (31 October 2015). "Enhanced succinic acid production in Aspergillus saccharolyticus by heterologous expression of fumarate reductase from Trypanosoma brucei". Applied Microbiology and Biotechnology. 100 (4): 1799–1809. doi:10.1007/s00253-015-7086-z. PMID 26521243. S2CID 16535228.
- Rana, Vandana; Eckard, Anahita D.; Teller, Philip; Ahring, Birgitte K. (February 2014). "On-site enzymes produced from Trichoderma reesei RUT-C30 and Aspergillus saccharolyticus for hydrolysis of wet exploded corn stover and loblolly pine". Bioresource Technology. 154: 282–289. doi:10.1016/j.biortech.2013.12.059. PMID 24412480.